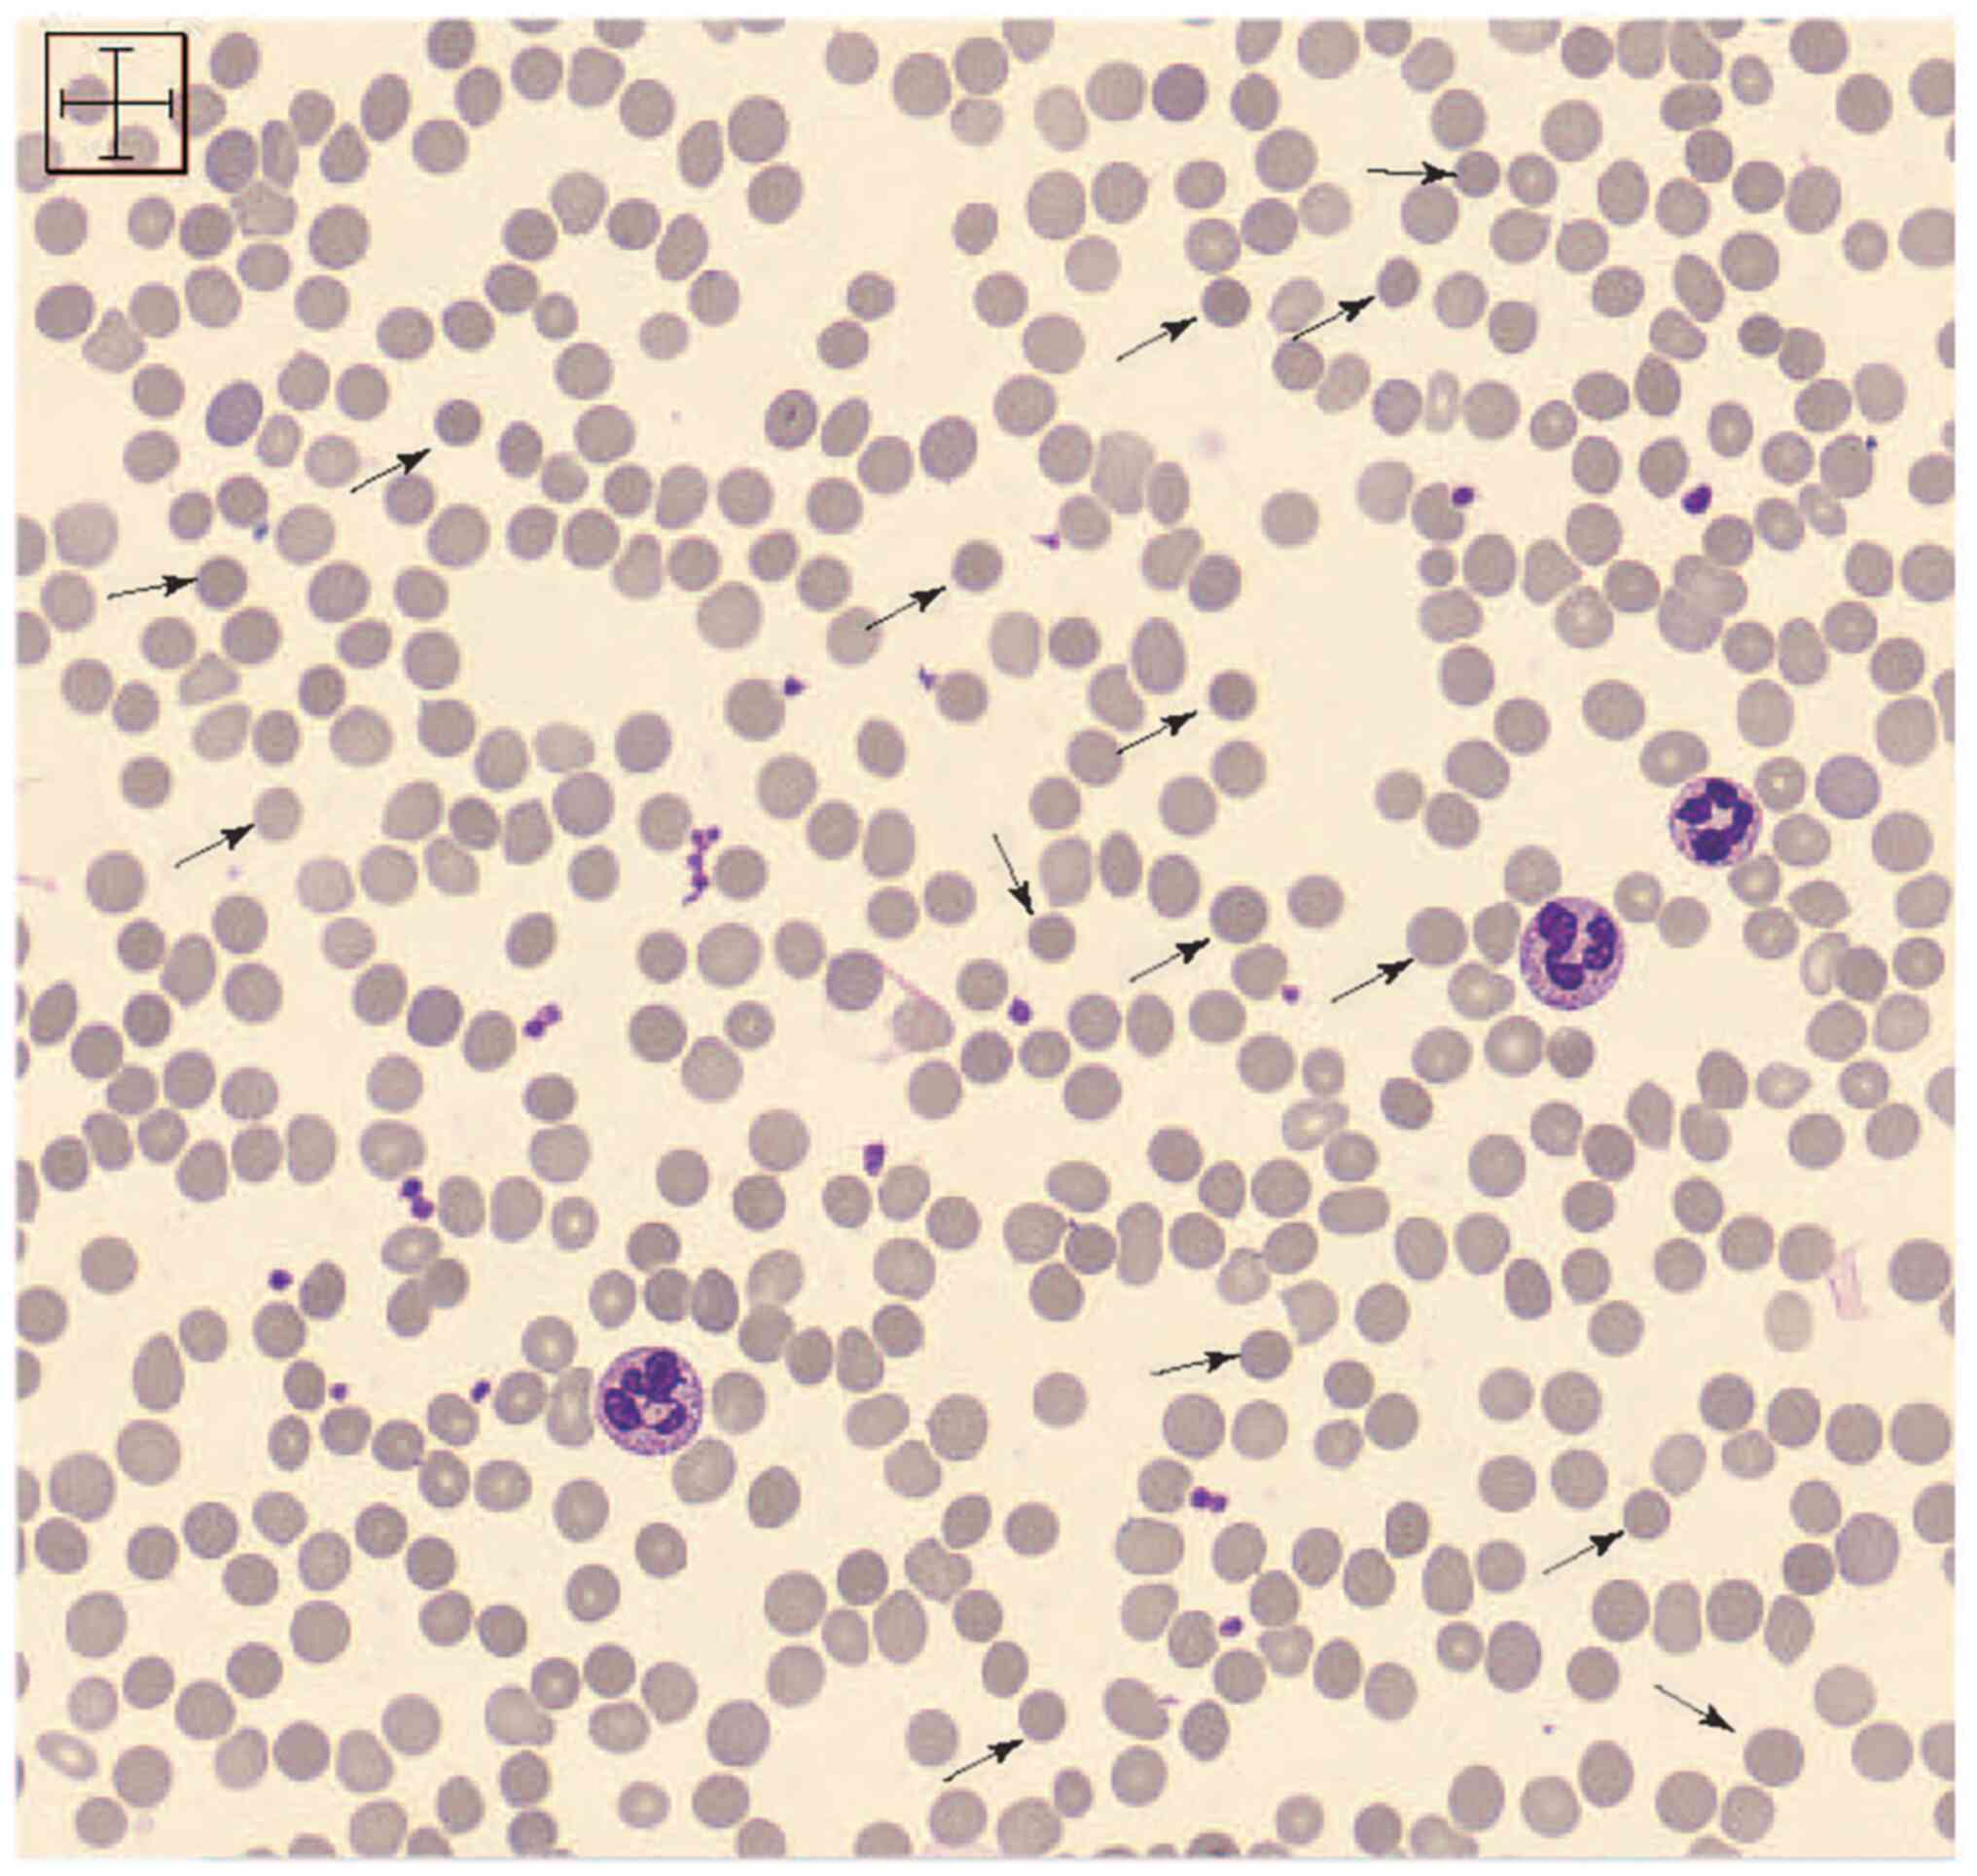

|
1
|
Perrotta S, Gallagher PG and Mohandas N:
Hereditary spherocytosis. Lancet. 372:1411–1426. 2008.PubMed/NCBI View Article : Google Scholar
|
|
2
|
Zamora EA and Schaefer CA: Hereditary
spherocytosis. In: StatPearls [Internet]. StatPearls Publishing,
Treasure Island, FL, 2022.
|
|
3
|
King MJ, Garçon L, Hoyer JD, Iolascon A,
Picard V, Stewart G, Bianchi P, Lee SH and Zanella A: International
Council for Standardization in Haematology. ICSH guidelines for the
laboratory diagnosis of nonimmune hereditary red cell membrane
disorders. Int J Lab Hematol. 37:304–325. 2015.PubMed/NCBI View Article : Google Scholar
|
|
4
|
Shim YJ, Jung HL, Shin HY, Kang HJ, Choi
JY, Hah JO, Lee JM, Lim YT, Yang EJ, Baek HJ, et al:
Epidemiological study of hereditary hemolytic anemia in the Korean
pediatric population during 1997-2016: A nationwide retrospective
cohort study. J Korean Med Sci. 35(e279)2020.PubMed/NCBI View Article : Google Scholar
|
|
5
|
Yawata Y, Kanzaki A, Yawata A, Doerfler W,
Ozcan R and Eber SW: Characteristic features of the genotype and
phenotype of hereditary spherocytosis in the Japanese population.
Int J Hematol. 71:118–135. 2000.PubMed/NCBI
|
|
6
|
Wang C, Cui Y, Li Y, Liu X and Han J: A
systematic review of hereditary spherocytosis reported in Chinese
biomedical journals from 1978 to 2013 and estimation of the
prevalence of the disease using a disease model. Intractable Rare
Dis Res. 4:76–81. 2015.PubMed/NCBI View Article : Google Scholar
|
|
7
|
Bolton-Maggs PH, Langer JC, Iolascon A,
Tittensor P and King MJ: General Haematology Task Force of the
British Committee for Standards in Haematology. Guidelines for the
diagnosis and management of hereditary spherocytosis-2011 update.
Br J Haematol. 156:37–49. 2012.PubMed/NCBI View Article : Google Scholar
|
|
8
|
Delaunay J: The molecular basis of
hereditary red cell membrane disorders. Blood Rev. 21:1–20.
2007.PubMed/NCBI View Article : Google Scholar
|
|
9
|
Narla J and Mohandas N: Red cell membrane
disorders. Int J Lab Hematol. 39 (Suppl 1):S47–S52. 2017.PubMed/NCBI View Article : Google Scholar
|
|
10
|
Tole S, Dhir P, Pugi J, Drury LJ, Butchart
S, Fantauzzi M, Langer JC, Baker JM, Blanchette VS, Kirby-Allen M
and Carcao MD: Genotype-phenotype correlation in children with
hereditary spherocytosis. Br J Haematol. 191:486–496.
2020.PubMed/NCBI View Article : Google Scholar
|
|
11
|
Eber SW, Armbrust R and Schröter W:
Variable clinical severity of hereditary spherocytosis: Relation to
erythrocytic spectrin concentration, osmotic fragility, and
autohemolysis. J Pediatr. 117:409–416. 1990.PubMed/NCBI View Article : Google Scholar
|
|
12
|
Friedman EW, Williams JC and Van Hook L:
Hereditary spherocytosis in the elderly. Am J Med. 84 (3 Pt
1):513–516. 1988.PubMed/NCBI View Article : Google Scholar
|
|
13
|
Whitfield CF, Follweiler JB,
Lopresti-Morrow L and Miller BA: Deficiency of alpha-spectrin
synthesis in burst-forming units-erythroid in lethal hereditary
spherocytosis. Blood. 78:3043–3051. 1991.PubMed/NCBI
|
|
14
|
Abdullah F, Zhang Y, Camp M, Rossberg MI,
Bathurst MA, Colombani PM, Casella JF, Nabaweesi R and Chang DC:
Splenectomy in hereditary spherocytosis: Review of 1,657 patients
and application of the pediatric quality indicators. Pediatr Blood
Cancer. 52:834–837. 2009.PubMed/NCBI View Article : Google Scholar
|
|
15
|
Alizai NK, Richards EM and Stringer MD: Is
cholecystectomy really an indication for concomitant splenectomy in
mild hereditary spherocytosis? Arch Dis Child. 95:596–599.
2010.PubMed/NCBI View Article : Google Scholar
|
|
16
|
Biesecker LG and Green RC: Diagnostic
clinical genome and exome sequencing. N Engl J Med. 370:2418–2425.
2014.PubMed/NCBI View Article : Google Scholar
|
|
17
|
Rabbani B, Mahdieh N, Hosomichi K, Nakaoka
H and Inoue I: Next-generation sequencing: Impact of exome
sequencing in characterizing Mendelian disorders. J Hum Genet.
57:621–632. 2012.PubMed/NCBI View Article : Google Scholar
|
|
18
|
Yang Y, Muzny DM, Xia F, Niu Z, Person R,
Ding Y, Ward P, Braxton A, Wang M, Buhay C, et al: Molecular
findings among patients referred for clinical whole-exome
sequencing. JAMA. 312:1870–1879. 2014.PubMed/NCBI View Article : Google Scholar
|
|
19
|
Wang X, Yi B, Mu K, Shen N, Zhu Y, Hu Q
and Lu Y: Identification of a novel de novo ANK1 R1426* nonsense
mutation in a Chinese family with hereditary spherocytosis by NGS.
Oncotarget. 8:96791–96797. 2017.PubMed/NCBI View Article : Google Scholar
|
|
20
|
Wei Y, He Y and Guo X: Clinical phenotype
and genetic analysis of twins with congenital coagulation factor V
deficiency. J Pediatr Hematol Oncol. 44:e482–e486. 2022.PubMed/NCBI View Article : Google Scholar
|
|
21
|
Kim Y, Park J and Kim M: Diagnostic
approaches for inherited hemolytic anemia in the genetic era. Blood
Res. 52:84–94. 2017.PubMed/NCBI View Article : Google Scholar
|
|
22
|
Xue J, He Q, Xie XJ, Su AL and Cao SB: A
clinical and experimental study of adult hereditary spherocytosis
in the Chinese population. Kaohsiung J Med Sci. 36:552–560.
2020.PubMed/NCBI View Article : Google Scholar
|
|
23
|
Wang R, Yang S, Xu M, Huang J, Liu H, Gu W
and Zhang X: Exome sequencing confirms molecular diagnoses in 38
Chinese families with hereditary spherocytosis. Sci China Life Sci.
61:947–953. 2018.PubMed/NCBI View Article : Google Scholar
|
|
24
|
Eber SW, Gonzalez JM, Lux ML, Scarpa AL,
Tse WT, Dornwell M, Herbers J, Kugler W, Ozcan R, Pekrun A, et al:
Ankyrin-1 mutations are a major cause of dominant and recessive
hereditary spherocytosis. Nat Genet. 13:214–218. 1996.PubMed/NCBI View Article : Google Scholar
|
|
25
|
Park J, Jeong DC, Yoo J, Jang W, Chae H,
Kim J, Kwon A, Choi H, Lee JW, Chung NG, et al: Mutational
characteristics of ANK1 and SPTB genes in hereditary spherocytosis.
Clin Genet. 90:69–78. 2016.PubMed/NCBI View Article : Google Scholar
|
|
26
|
Qin L, Nie Y, Zhang H, Chen L, Zhang D,
Lin Y and Ru K: Identification of new mutations in patients with
hereditary spherocytosis by next-generation sequencing. J Hum
Genet. 65:427–434. 2020.PubMed/NCBI View Article : Google Scholar
|
|
27
|
Salomao M, Zhang X, Yang Y, Lee S, Hartwig
JH, Chasis JA, Mohandas N and An X: Protein 4.1R-dependent
multiprotein complex: New insights into the structural organization
of the red blood cell membrane. Proc Natl Acad Sci USA.
105:8026–8031. 2008.PubMed/NCBI View Article : Google Scholar
|
|
28
|
Lux SE, John KM and Bennett V: Analysis of
cDNA for human erythrocyte ankyrin indicates a repeated structure
with homology to tissue-differentiation and cell-cycle control
proteins. Nature. 344:36–42. 1990.PubMed/NCBI View
Article : Google Scholar
|
|
29
|
Wang X, Zhang A, Huang M, Chen L, Hu Q, Lu
Y and Cheng L: Genetic and clinical characteristics of patients
with hereditary spherocytosis in Hubei Province of China. Front
Genet. 11(953)2020.PubMed/NCBI View Article : Google Scholar
|
|
30
|
Wang D, Song L, Shen L, Zhang K, Lv Y, Gao
M, Ma J, Wan Y, Gai Z and Liu Y: Mutational characteristics of
causative genes in Chinese hereditary spherocytosis patients: A
report on fourteen cases and a review of the literature. Front
Pharmacol. 12(644352)2021.PubMed/NCBI View Article : Google Scholar
|
|
31
|
Aggarwal A, Jamwal M, Sharma P, Sachdeva
MUS, Bansal D, Malhotra P and Das R: Deciphering molecular
heterogeneity of Indian families with hereditary spherocytosis
using targeted next-generation sequencing: First South Asian study.
Br J Haematol. 188:784–795. 2020.PubMed/NCBI View Article : Google Scholar
|
|
32
|
Michaels LA, Cohen AR, Zhao H, Raphael RI
and Manno CS: Screening for hereditary spherocytosis by use of
automated erythrocyte indexes. J Pediatr. 130:957–960.
1997.PubMed/NCBI View Article : Google Scholar
|
|
33
|
Kowdley KV, Brown KE, Ahn J and Sundaram
V: ACG clinical guideline: Hereditary hemochromatosis. Am J
Gastroenterol. 114:1202–1218. 2019.PubMed/NCBI View Article : Google Scholar
|
|
34
|
Llaudet-Planas E, Vives-Corrons JL,
Rizzuto V, Gómez-Ramírez P, Sevilla Navarro J, Coll Sibina MT,
García-Bernal M, Ruiz Llobet A, Badell I, Velasco-Puyó P, et al:
Osmotic gradient ektacytometry: A valuable screening test for
hereditary spherocytosis and other red blood cell membrane
disorders. Int J Lab Hematol. 40:94–102. 2018.PubMed/NCBI View Article : Google Scholar
|